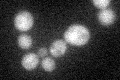
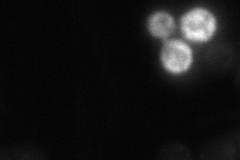
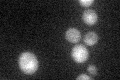

View description
Phosphoribosylanthranilate isomerase that catalyzes the third step in tryptophan biosynthesis; in 2004, the sequence of TRP1 from strain S228C was updated by changing the previously annotated internal STOP (TAA) to serine (TCA)
Localization:
Intensity:
Fold change:
Significance:
-
C’ GFP library in SD
cytosol31.71 -
N' NOP1pr-GFP in SD

below threshold15.8551 -
N' TEF2pr-mCherry in SD

below threshold6.31222 -
N' NATIVEpr-GFP in SD
below threshold17.4984 -
N' TEF2pr-VC and Cyto-VN in SD

#N/A0 -
C’ GFP library in SD+DTT

cytosol32.11.01No -
C’ GFP library in SD+H2O2

cytosol25.710.81No -
C’ GFP library in Starvation Media
cytosol34.431.08No -
C’ GFP library on the background of Pup2-DaMP

cytosol -
C’ GFP library on the background of CCT mutant

cytosol34.14941.07659No
